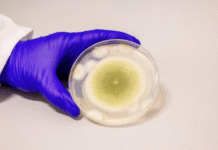
Researchers Transform Toxic Fungus into Promising Anti-Cancer Compound

Biological sex at birth isn’t random, study finds
A child’s biological sex at birth may not be a 50-50 toss-up, according to a new study from Harvard T.H. Chan School of Public...
Study Uncovers How Eye Contact Shapes Communication With Humans—and Robots
NEW DELHI-- The timing of eye contact plays a crucial role in how we communicate—not just with people, but with robots as well—according to a...
Shubhanshu Shukla: India’s New Star in Space
NEW DELHI-- After more than four decades since Rakesh Sharma made history in 1984, India has once again sent an astronaut into space —...
Shubhanshu Shukla Experiments with Sprouting Green Gram, Fenugreek Seeds in Space
NEW DELHI-- Indian astronaut Shubhanshu Shukla, currently aboard the International Space Station (ISS) as part of Axiom Space Mission 4, has conducted groundbreaking experiments involving...
Indian Astronomers Discover Tiny Plasma Loops in Sun’s Corona, Unlocking New Clues to Solar...
NEW DELHI-- In a breakthrough that could unlock some of the Sun’s most elusive secrets, astronomers at the Indian Institute of Astrophysics (IIA) have discovered...
Indian Astronaut Shubhanshu Shukla Developing Brain-Computer Interface Aboard ISS
New Delhi-- Shubhanshu Shukla, the first Indian astronaut to reach the International Space Station (ISS), is now pioneering the development of a brain-computer interface...
Shubhanshu Shukla Leads Groundbreaking Experiment on Muscle Loss in Space
New Delhi-- Indian Air Force Group Captain Shubhanshu Shukla is leading a critical experiment aboard the International Space Station (ISS) to study muscle health...
Australian Scientists Develop Groundbreaking Genetic Barcoding Tool to Decode Early Human Development
New Delhi-- Australian researchers have unveiled a powerful new genetic barcoding technology that allows scientists to trace the developmental journey of individual cells in...
Over 500 Bird Species at Risk of Extinction Within 100 Years: Study
New Delhi-- More than 500 bird species could face extinction over the next century due to climate change and habitat loss, according to a new...
Researchers Transform Toxic Fungus into Promising Anti-Cancer Compound
New Delhi-- In a groundbreaking development, a team of U.S. scientists has converted a deadly fungus into a potential cancer-fighting agent, offering new hope...